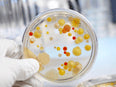
Fosamax Scare: ABC Shines Light on Spontaneously Breaking Bones

Another drug debacle is blowing up in the corrupt face of the FDA. I have reported for years that Fosamax and similar drugs are one of the greatest con jobs ever perpetrated on women (statins and mental health drugs hold the top spots). Now ABC News is highlighting the fact that women who have faithfully taken their Fosamax, which is known to create highly disorganized and chaotic bone structure, are experiencing spontaneously breaking femur bones from doing virtually nothing. In other words, one of the strongest bones in the body is disintegrating from the regular long-term use of Fosamax.
The use of bisphosphonate drugs to prevent osteoporosis is fraud. At the center of the fraud is the FDA and their friends in Big Pharma. Following the ABC exposé the FDA now says it will look into the matter further – isn’t it interesting what a little public exposure will do. Regardless, the corrupt FDA looking into the problem is like having a fox checking on the status of a henhouse. In addition to the FDA and Big Pharma, the medical profession itself is a major perpetrator of this fraud. The information has been available for decades as to the extreme damage these drugs cause healthy bones. There is no excuse for the ineptitude of the Western medical profession. This isn’t a small joke. These are major crimes against women that cause a serious deterioration of health. Be clear about who is responsible: FDA management, Big Pharma, and prescribing physicians.
Fosamax Scare: ABC Shines Light on Spontaneously Breaking Bones
Byron J. Richards, Board Certified Clinical Nutritionist